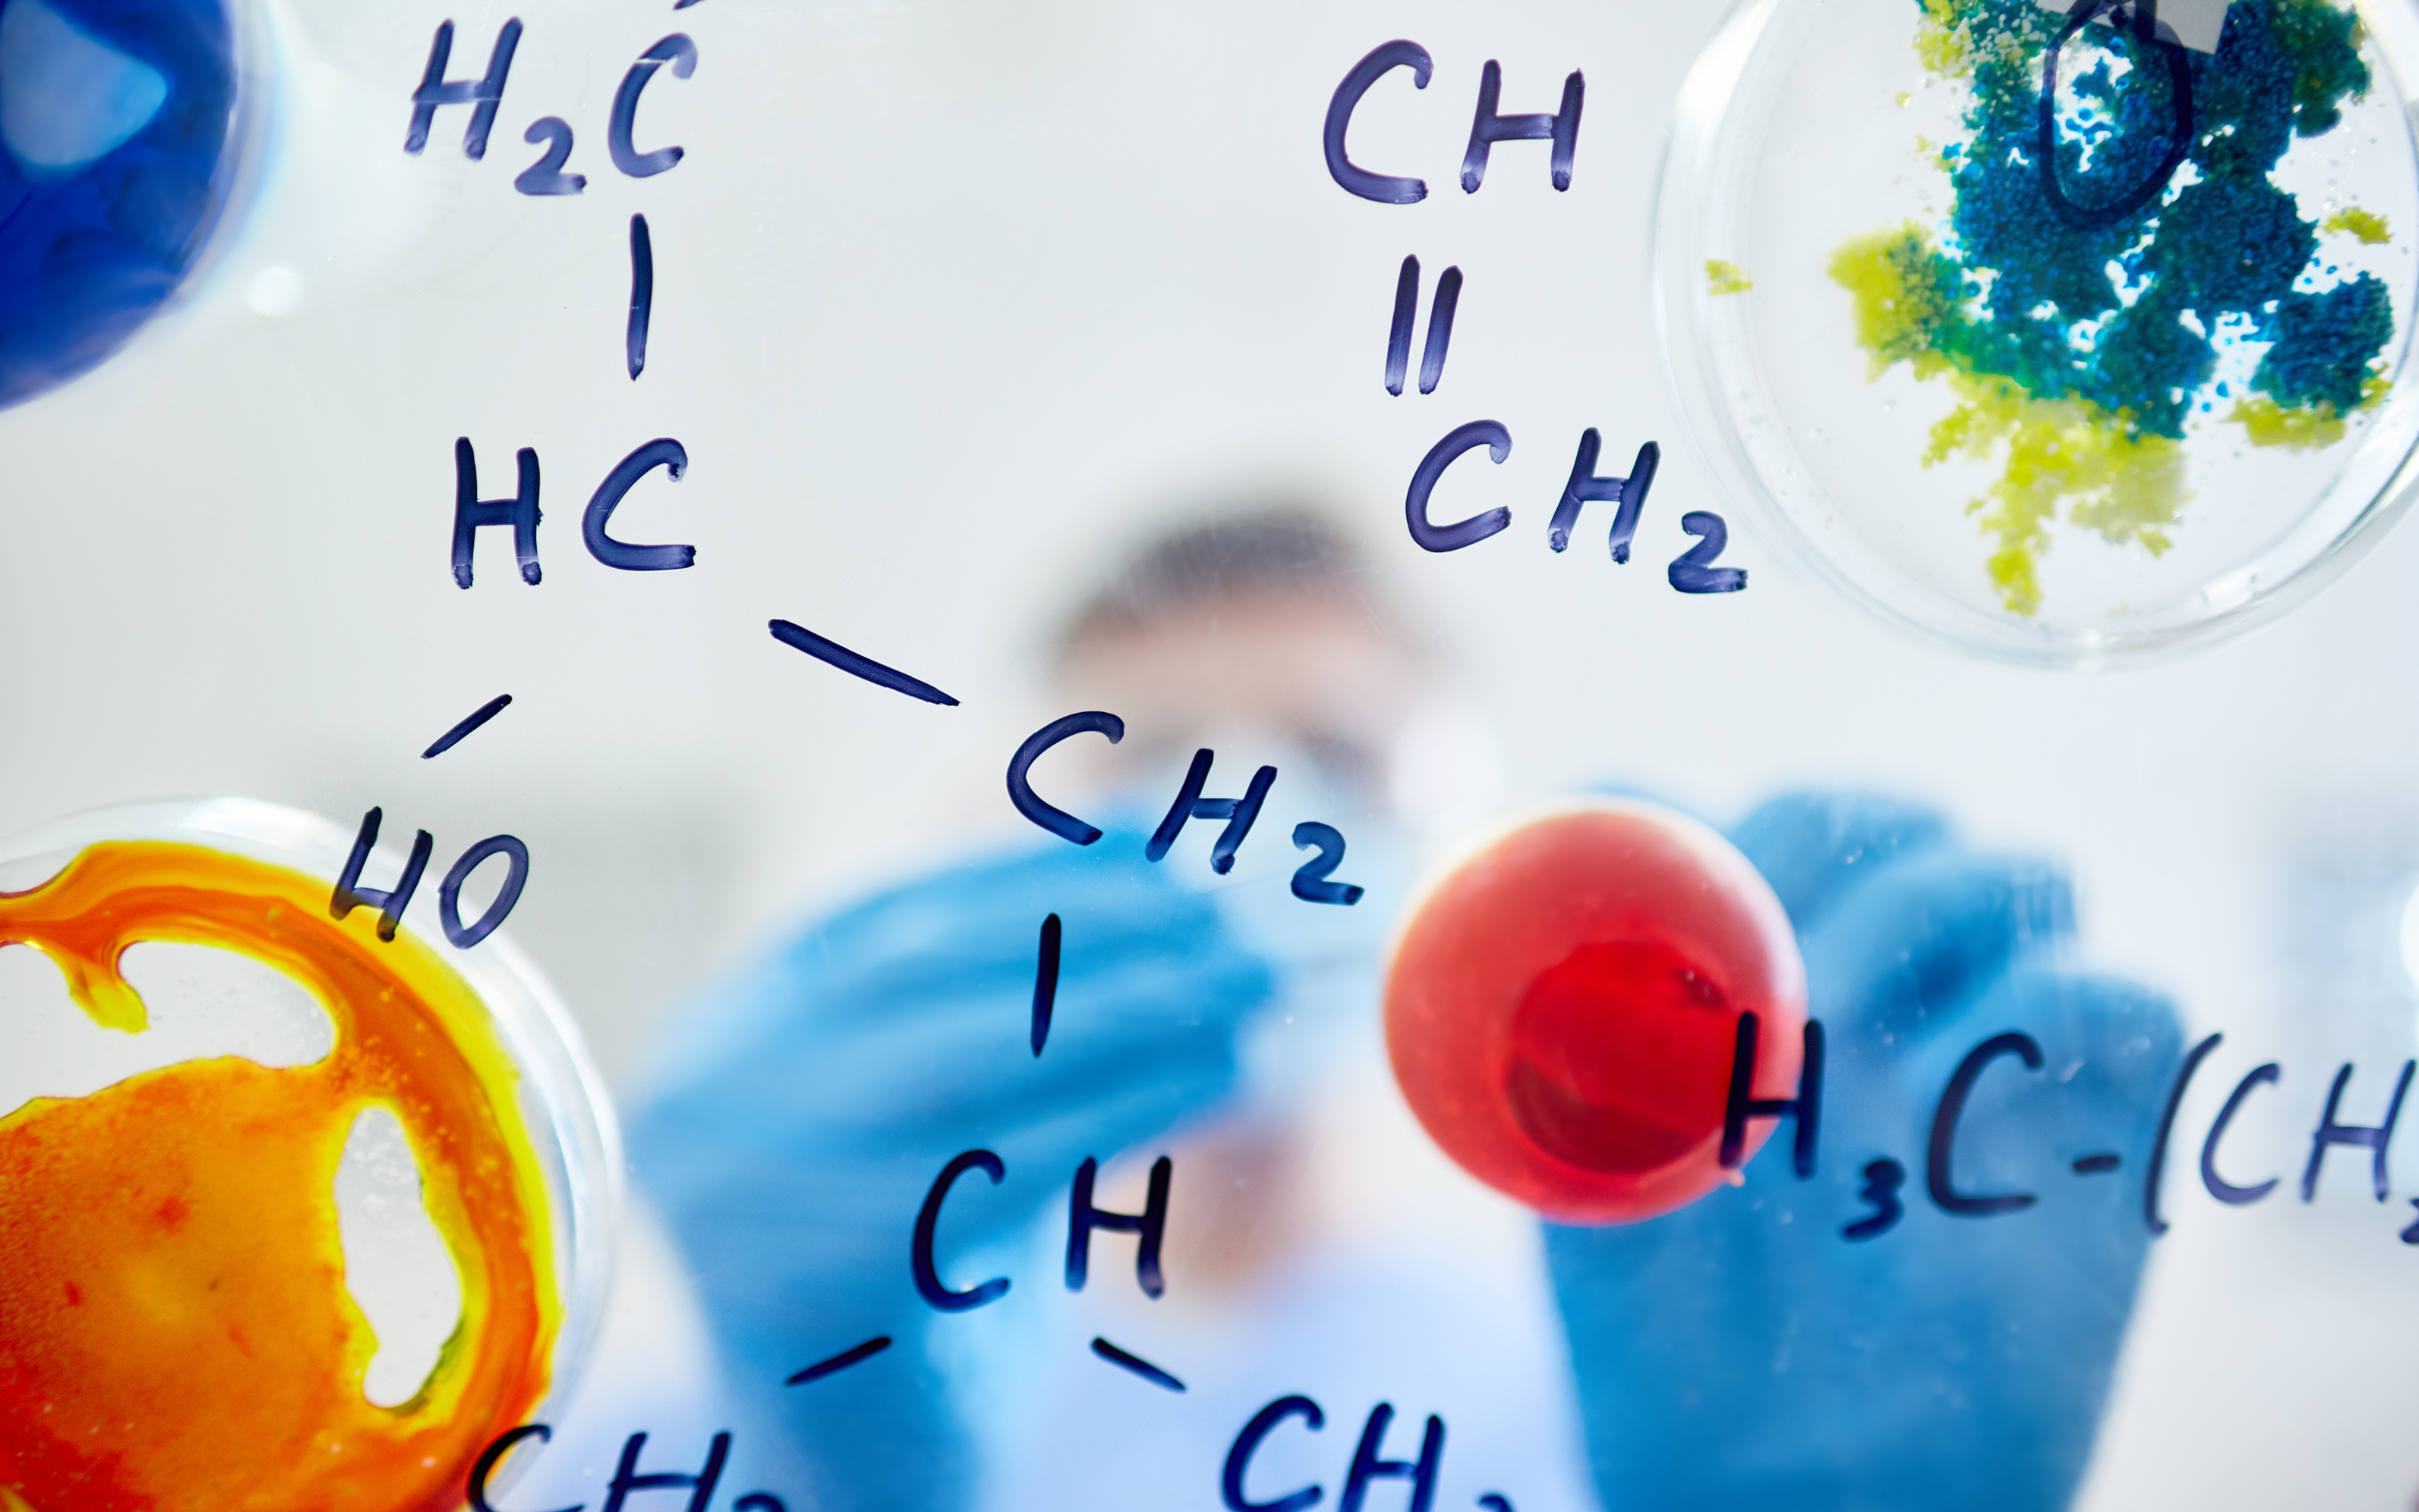

Wat doet de stof alkylnitrieten?
Veel mensen vragen zich af: wat doet de stof alkylnitrieten precies? Bij popperskopen.nl leggen we dit duidelijk uit. Alkylnitrieten zijn vluchtige vloeistoffen die je inhaleert, waardoor je een kortdurende roes en merkbare spierontspanning ervaart. Dit verklaart waarom ze populair zijn in recreatieve settingen.Oorspronkelijk werden alkylnitrieten, zoals amyl-nitriet, medisch gebruikt als vaatverwijder bij bijvoorbeeld angina. Tegenwoordig worden ze vooral recreatief gebruikt. In Nederland vallen verschillende varianten onder de Warenwet of Geneesmiddelenwet. Dat betekent dat verkoop “voor menselijke consumptie” niet is toegestaan en dat de wettelijke status afhangt van de exacte samenstelling van het flesje.
Hoe werkt de stof alkylnitrieten in je lichaam?
Als je je afvraagt wat doet de stof alkylnitrieten, dan is het belangrijk om te begrijpen hoe deze chemisch en biologisch werkt. Alkylnitrieten gedragen zich in het lichaam als stikstofmonoxide (NO)-donoren. Dit betekent dat ze de aanmaak van NO stimuleren. NO activeert het enzym guanylaatcyclase, wat de hoeveelheid cGMP in je cellen verhoogt. Het resultaat? Ontspanning van gladde spieren in je bloedvaten én andere spiergroepen.Door deze werking treedt er een vaatverwijding op: je bloeddruk daalt tijdelijk, je hartslag versnelt reflexmatig, en spieren zoals de anale sfincter ontspannen. Dit biologische effect verklaart veel van de ervaringen die gebruikers rapporteren bij het inhaleren van alkylnitrieten.

Waarom voel je een “rush”?
Een van de meest opvallende effecten van alkylnitrieten is de intense, maar kortdurende “rush”. Deze ontstaat doordat je bloedvaten razendsnel verwijden, waardoor er een plotselinge stroom van warmte, lichte duizeligheid en een euforisch gevoel ontstaat. Binnen enkele seconden voel je dit effect, maar het ebt meestal binnen een paar minuten weer weg.Directe effecten van alkylnitrieten
Veel mensen willen weten: wat doet de stof alkylnitrieten direct na gebruik? Binnen 10 tot 30 seconden na inhalatie merk je de eerste effecten, die meestal 1 tot 5 minuten aanhouden.Gewenste effecten
- Een warm en tintelend gevoel door het hele lichaam
- De bekende “head rush” met kortstondige euforie
- Ontspanning van gladde spieren, waaronder de anale sfincter – dit kan receptieve anale seks makkelijker en aangenamer doen aanvoelen
Ongewenste effecten en bijwerkingen
Naast de gewenste effecten kan de stof ook minder prettige reacties veroorzaken. Mogelijke bijwerkingen zijn:- Hoofdpijn (soms langdurig, tot meerdere dagen)
- Duizeligheid en misselijkheid
- Hartkloppingen of een opgejaagd gevoel
- Flauwvallen door een plotselinge bloeddrukdaling
- Tijdelijk wazig zien
Belangrijke gezondheidsrisico’s van alkylnitrieten
Wanneer je wilt begrijpen wat doet de stof alkylnitrieten, is het belangrijk niet alleen de directe effecten te kennen, maar ook de mogelijke gezondheidsrisico’s. Hieronder vind je de belangrijkste risico’s die in wetenschappelijk onderzoek en praktijk zijn beschreven.1. Oogschade (“poppers-maculopathie”)
Een deel van de gebruikers ontwikkelt centrale visusklachten, zoals:- Wazig zien in het midden van het blikveld
- Donkere vlekken (scotoma)
- Overgevoeligheid voor licht (fotofobie)
2. Methemoglobinemie (levensbedreigend, vooral bij inname)
Als de vloeistof wordt ingeslikt of bij zeer hoge blootstelling, kan hemoglobine oxideren tot methemoglobine. Hierdoor kan het bloed minder zuurstof vervoeren, met symptomen als:- Grijzige of blauwige verkleuring van huid en lippen
- Kortademigheid en sufheid
- Een zuurstofsaturatie rond ~85% die niet verbetert met extra zuurstof
3. Heftig lage bloeddruk & hartritmestoornissen
De sterke vaatverwijding door alkylnitrieten kan leiden tot:- Flauwvallen (syncope)
- Ritmestoornissen
- Ischemie bij kwetsbare harten
4. Huid- en luchtwegirritatie, chemische brandwonden & brandgevaar
De vloeistof is irriterend en zeer brandbaar. Risico’s zijn onder andere:- Brandwonden rond neus, lippen of ogen bij morsen
- Oogschade (keratitis) bij direct contact
- Luchtwegirritatie bij dampblootstelling
- Brandgevaar bij gebruik in de buurt van open vuur
Kritieke interacties: mixen met alkylnitrieten kan gevaarlijk zijn
Als je wilt begrijpen wat doet de stof alkylnitrieten, dan hoort daar ook bij dat je weet welke gevaarlijke interacties kunnen optreden wanneer je deze middelen combineert met andere stoffen. Sommige combinaties zijn namelijk ronduit levensgevaarlijk.PDE5-remmers (Viagra, Cialis, Levitra)
Het is absoluut verboden om alkylnitrieten te combineren met PDE5-remmers zoals:- Sildenafil (Viagra)
- Tadalafil (Cialis)
- Vardenafil (Levitra)
Hoewel er soms adviezen circuleren om minimaal 24–48 uur te wachten (afhankelijk van middel en dosering), blijft het veiligste advies om helemaal niet te mixen.
Andere vaatverwijders, antihypertensiva en alcohol
Ook andere middelen die de bloeddruk verlagen, zoals antihypertensiva of alcohol, versterken de kans op:- Heftig lage bloeddruk
- Flauwvallen
- Duizeligheid en evenwichtsverlies
Wie loopt extra risico bij het gebruik van alkylnitrieten?
Wanneer je onderzoekt wat doet de stof alkylnitrieten, is het belangrijk te weten dat sommige groepen mensen extra kwetsbaar zijn voor de effecten en risico’s. Voor hen kan gebruik sneller of ernstiger tot complicaties leiden.Risicogroepen:
- Mensen met hart- en vaatziekten
Door de sterke vaatverwijding kunnen hartritmestoornissen, ischemie en extreme bloeddrukdalingen optreden. - Mensen met ernstige anemie
Een laag zuurstoftransport in het bloed kan verergeren door de effecten van alkylnitrieten. - Mensen met G6PD-deficiëntie
Vooral riskant bij complicaties zoals methemoglobinemie, omdat standaardbehandelingen (methylene blue) gevaarlijk kunnen zijn. - Mensen met bestaande oogproblemen
Bijvoorbeeld glaucoom of aanleg voor maculaklachten. Bij hen is het risico op oogschade en blijvende visusproblemen groter.
Welke stoffen zitten er in poppers?
Wie zich afvraagt wat doet de stof alkylnitrieten komt al snel bij de vraag: welke varianten zitten er eigenlijk in poppers? Het etiket vertelt helaas lang niet altijd de hele waarheid.In de EU is isobutylnitriet verboden vanwege de classificatie als mogelijk kankerverwekkend. Daardoor gebruiken fabrikanten tegenwoordig vaker isopropylnitriet of varianten zoals (iso)amyl- of pentylnitriet. Juist isopropylnitriet wordt echter herhaaldelijk in verband gebracht met poppers-maculopathie (oogschade).
Onafhankelijke laboratoriumonderzoeken hebben bovendien meermaals aangetoond dat de feitelijke inhoud van flesjes niet altijd overeenkomt met wat er op het etiket staat. Dit maakt het extra belangrijk om goed geïnformeerd te zijn over wat de stof alkylnitrieten doet en welke varianten eraan verbonden zijn.
Situatie in Nederland & de EU
Wie wil weten wat doet de stof alkylnitrieten moet ook begrijpen hoe de wetgeving in Nederland en de EU eruitziet.Nederland
In Nederland staan poppers niet op de Opiumlijst. Toch is verkoop voor consumptie verboden onder de Warenwet en de Geneesmiddelenwet. In de praktijk zijn poppers nog steeds online verkrijgbaar en soms “onder de toonbank” te koop. Let wel: het bezit kan problemen opleveren als jouw flesje een variant bevat die onder de Geneesmiddelenwet valt.Europese Unie
Binnen de EU is isobutylnitriet verboden, vanwege de kankerverwekkende classificatie. Hierdoor schakelden veel fabrikanten over op andere nitrieten, zoals isopropylnitriet. Juist deze variant wordt in verschillende studies gekoppeld aan maculopathie (oogschade).Medisch gebruik van alkylnitrieten (historisch en context)
Om te begrijpen wat doet de stof alkylnitrieten, is het interessant om ook naar de medische achtergrond te kijken.Historisch gezien werd amyl-nitriet gebruikt als voorgeschreven vaatverwijder. In sommige landen is het nog steeds geregistreerd voor medisch gebruik, maar bijvoorbeeld in het Verenigd Koninkrijk niet meer.
Belangrijk om te benadrukken: de flesjes die consumenten als poppers kopen, hebben geen enkele medische goedkeuring. Integendeel, gezondheidsautoriteiten waarschuwen juist expliciet tegen het inhaleren of inslikken van deze stoffen vanwege de risico’s en bijwerkingen.
Samenvatting: risico’s van alkylnitrieten
Om snel inzicht te krijgen in wat doet de stof alkylnitrieten en welke risico’s daarbij horen, vind je hieronder een overzicht in matrixvorm.Kortetermijn – gewenste effecten
- Warm gevoel en de typische kortdurende “rush”
- Ontspanning van spieren, waaronder de anale sfincter
Kortetermijn – ongewenste effecten
- Hoofdpijn
- Duizeligheid of flauwvallen
- Tijdelijk wazig zien
Ernstige maar zeldzame risico’s
- Maculopathie: blijvende of langdurige visusklachten (oogschade)
- Methemoglobinemie: levensbedreigend zuurstoftekort, vooral bij inslikken
???? Altijd direct stoppen en medische hulp zoeken bij klachten
No-go combinaties
- Strikt niet combineren met PDE5-remmers zoals Viagra, Cialis of Levitra, of andere nitraten. Dit kan leiden tot levensgevaarlijke bloeddrukdalingen.
Praktische harm-reduction tips
Het veiligste advies is natuurlijk: gebruik geen alkylnitrieten. Toch begrijpen we dat sommige mensen zich afvragen wat doet de stof alkylnitrieten en besluiten het alsnog te proberen. Daarom hier een aantal praktische harm-reduction tips om de risico’s zoveel mogelijk te beperken:- Nooit drinken of inslikken
Inslikken is levensgevaarlijk. Bel direct 112 of ga naar de SEH bij inname. - Niet combineren met PDE5-remmers of veel alcohol
Middelen zoals Viagra, Cialis of Levitra én alcohol of antihypertensiva verhogen het risico op een gevaarlijke bloeddrukdaling. - Gebruik zittend of liggend
Dit verkleint de kans op vallen of flauwvallen. Zorg dat je voldoende gehydrateerd bent. - Voorkom huid- en oogcontact
Komt de vloeistof toch op huid of in ogen, spoel direct met veel water. Houd poppers altijd uit de buurt van vuur: de vloeistof is zeer brandbaar. - Stop direct bij alarmsymptomen
Zoek medische hulp bij:- Wazig centraal zien of een donkere vlek in je zicht
- Blauw/grijze verkleuring van huid of lippen
- Ernstige hoofdpijn of kortademigheid
- Flauwvallen of bewustzijnsverlies
Bronnen & verdere informatie
Bij popperskopen.nl vinden we het belangrijk dat jij betrouwbare en actuele informatie krijgt over wat doet de stof alkylnitrieten en de risico’s die daarbij horen. Hieronder vind je een selectie van gebruikte bronnen:- Trimbos Instituut / Drugsinfo – informatie over effecten, risico’s en Nederlandse wetgeving
- Jellinek (NL) – uitleg over werking, duur, risico’s en praktische tips
- Wetenschappelijke literatuur – systematische reviews en casuïstiek over poppers-maculopathie (o.a. British Journal of Ophthalmology, Eye, en vakbladen voor optometrie)
- FDA-label sildenafil (Viagra) – officiële contra-indicatie van gelijktijdig gebruik met nitraten/nitrieten
- Casus & reviews methemoglobinemie – beschrijvingen van vergiftiging door poppers, inclusief gevallen na ingestie
- Farmacologisch mechanisme – rol van NO → cGMP in de ontspanning van gladde spieren
- EU-context – regelgeving rond het verbod op isobutylnitriet en de verschuiving naar isopropylnitriet
Bij popperskopen.nl vinden we het belangrijk dat jij niet alleen weet wat de stof alkylnitrieten doet, maar ook welke ongewenste effecten kunnen optreden. Zo kun je een weloverwogen keuze maken en beter begrijpen hoe deze middelen inwerken op je lichaam.
Reacties
Let op: HTML wordt niet vertaald!